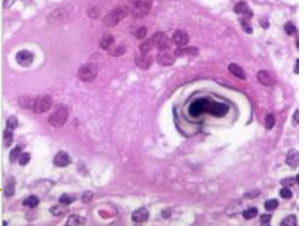
term image

APE I-2. Patología no tumoral aparato respiratorio II
0.0(0)
Studied by 0 peopleCard Sorting
1/26
Earn XP
Description and Tags
pinto pinto gorgorito feat Hardisson
Last updated 7:10 PM on 4/13/26
Name | Mastery | Learn | Test | Matching | Spaced | Call with Kai |
|---|
No analytics yet
Send a link to your students to track their progress
27 Terms
1
New cards

Enfisema centrolobulillar
2
New cards

Enfisema Panacinar o panlobulillar
3
New cards

Enfisema Distal, paraseptal o localizado
4
New cards

Enfisema irregular
5
New cards

Bronquitis crónica
6
New cards

Asma macro
7
New cards

Asma micro
8
New cards

Espirales de Curschmann
9
New cards


Asma: Remodelamiento de la pared bronquial
10
New cards

Cristales de Charcot-Leyden
11
New cards



Bronquiectasias
12
New cards

Bronquiectasias: cilindricas
13
New cards


Bronquiectasias: varicosas
14
New cards

Bronquiectasias: saculares
15
New cards

Bronquiectasias: micro
16
New cards

FPI: macro
17
New cards

FPI: micro
18
New cards

NII/NINE
19
New cards

NOC
20
New cards

Silicosis
21
New cards

Asbestosis
22
New cards

Neumonía intersticial descamativa
23
New cards

Sarcoidosis
24
New cards

Cuerpos asteroides
25
New cards
Cuerpos de Schaumann
26
New cards

Alveolitis alérgica (AAE)/neumonitis por hipersensibilidad
27
New cards


Proteinosis alveolar pulmonar (PAP)